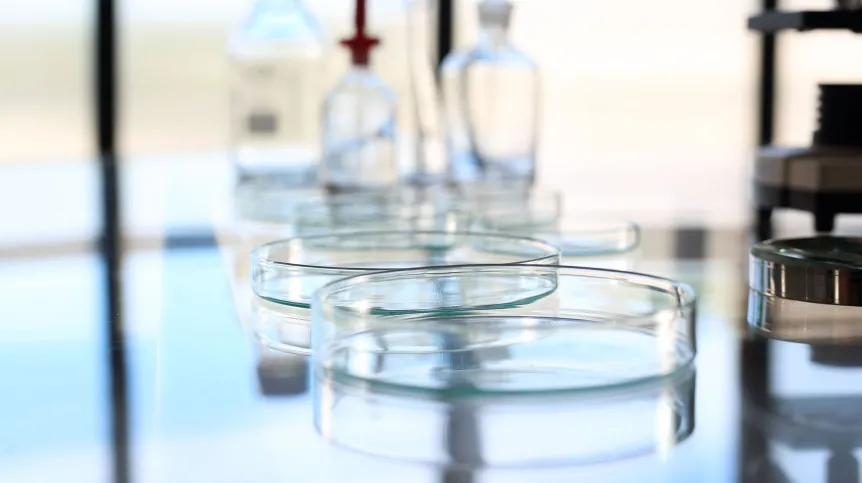

Resort nauki planuje nowym rozporządzeniem skrócić czas na składanie dokumentów dotyczących utrzymania aparatury naukowo-badawczej, stanowiska badawczego oraz specjalnej infrastruktury informatycznej. Zamiast do sierpnia - uczelnie i instytuty będą mieć czas do końca czerwca br.
W poniedziałek Ministerstwo Nauki i Szkolnictwa Wyższego opublikowało w Rządowym Centrum Legislacji (RCL) projekt zmiany rozporządzenia w sprawie szczegółowych kryteriów i trybu przyznawania środków finansowych na utrzymanie aparatury naukowo-badawczej, stanowiska badawczego i specjalnej infrastruktury informatycznej oraz oceny raportu z ich wykorzystania.
Nowe przepisy, które planuje wprowadzić resort nauki przewidują m.in., że uczelnie i instytuty będą mieć w tym roku mniej czasu na składanie dokumentów dotyczących finansowania m.in. działających na uczelniach dużych urządzeń badawczych czy superkomputerów. Skrócić się ma też czas, jaki wnioskodawcy będą mieli na usunięcie braków formalnych w dokumentacji (z 14 do 7 dni).
Chodzi o koszty stałe, które uczelnie i instytuty muszą ponosić w sposób ciągły - m.in. na działające w ich strukturach reaktory, akceleratory, serwerownie. Co roku ministerstwo obsługuje 300 takich wniosków. Dokumenty te są oceniane przez ministerialny Zespół doradczy do spraw infrastruktury badawczej. A układanie list rankingowych i wybór finansowanych projektów jest - jak ocenia resort nauki - czasochłonne.
Dokumenty w tej sprawie takie składano do tej pory do 31 sierpnia każdego roku poprzedzającego rok przyznania dotacji. Ministerstwo chce jednak co roku wcześniej otrzymywać te dokumenty do rozpatrzenia. Projekt rozporządzenia zakłada, że jeszcze w tym roku czas na przygotowanie tej dokumentacji będzie do końca czerwca, a w przyszłym roku - do końca kwietnia.
Ministerstwo zwraca uwagę, że istnieją mankamenty w procedurze wykorzystywania środków finansowych przyznawanych w związku z tym rozporządzeniem: “Wnioskodawcy, szacując wartości środków finansowych planowanych do poniesienia w okresie objętym wnioskiem, biorą pod uwagę wykorzystywanie tych środków przez okres pełnego roku kalendarzowego. Tymczasem decyzje dotyczące przyznania środków finansowych na utrzymanie aparatury (...) są podejmowane w drugiej połowie pierwszego roku finansowania, co uniemożliwia pokrycie kosztów ponoszonych od początku tego roku”.
Projekt rozporządzenia zakłada też, że korespondencja w sprawie dokumentacji może być doręczana przez system teleinformatyczny OSF.
Ministerstwo proponuje, by projektowane rozporządzenie weszło w życie 1 czerwca 2025 r. Czas na przesyłanie uwag do projektu mija 22 kwietnia br.(PAP)
lt/ bar/
Fundacja PAP zezwala na bezpłatny przedruk artykułów z Serwisu Nauka w Polsce pod warunkiem mailowego poinformowania nas raz w miesiącu o fakcie korzystania z serwisu oraz podania źródła artykułu. W portalach i serwisach internetowych prosimy o zamieszczenie podlinkowanego adresu: Źródło: naukawpolsce.pl, a w czasopismach adnotacji: Źródło: Serwis Nauka w Polsce - naukawpolsce.pl. Powyższe zezwolenie nie dotyczy: informacji z kategorii "Świat" oraz wszelkich fotografii i materiałów wideo.